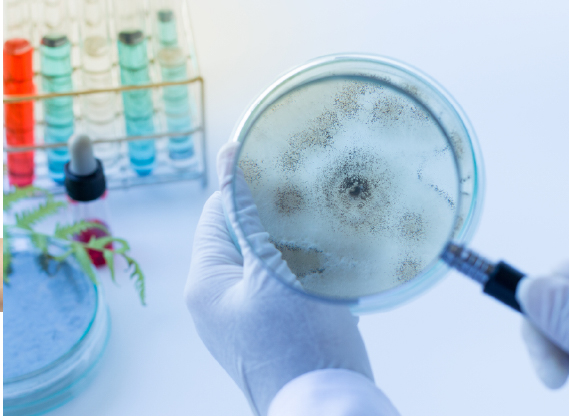

Tin tức
4 Sự thật gây sốc về nước đóng chai nhiều người uống hàng ngày mà không biết
Nước đóng chai không thật sự tốt như bạn nghĩ. Bạn không nên tái sử dụng các loại chai nhựa vì chúng có thể thôi ra các loại hóa chất nguy hiểm. Đây là lý do tại sao bạn phải quan tâm đến các biểu tượng dưới chai
Hiện nay, nước đóng chai là một trong những sản phẩm được người tiêu dùng ưa chuộng vì tính tiện dụng của nó. Tuy nhiên, ít ai biết một loạt các sự thật liên quan đến loại nước uống này.
1. Tuyệt đối không được dùng lại chai nhựa đã qua sử dụng

Bạn không nên tái sử dụng các loại chai nhựa vì chúng có thể thôi ra các loại hóa chất nguy hiểm. Đây là lý do tại sao bạn phải quan tâm đến các biểu tượng dưới chai. Chẳng hạn nếu bạn nhận thấy chai nhựa có ký hiệu hình tam giác có số bên trong, đây là biểu tượng của loại nhựa nguyên liệu chế tạo chai. Chai được đánh dấu với ký hiệu “1” (PET hoặc PETE) chỉ an toàn khi sử dụng 1 lần.

Nguyên nhân là trong môi trường có oxy, nếu chai nhựa được phơi nắng, chất dẻo sẽ bắt đầu giải phóng các chất độc hại. Sau đó, các chất này có thể sẽ ngấm vào nước. Bạn cũng nên tránh các loại chai có ký hiệu là “3” và “7” (PVC và PC) vì chúng có chứa các chất độc có thể xâm nhập vào thực phẩm và đồ uống. Khi sử dụng loại chai có ký hiệu này, chúng rất nguy hiểm đến sức khỏe lâu dài của bạn. Tái sử dụng các loại chai nhựa này trong thời gian dài có thể tăng nguy cơ nhiều bệnh nguy hiểm, đặc biệt là các căn bệnh ung thư. Tuy nhiên, có một số loại chai an toàn có thể tái sử dụng như: loại chai có ký hiệu “2” và “4” được làm từ polyethylene có thể tái sử dụng. Ngoài ra, các chai làm bằng polypropylene được đánh dấu bằng ký hiệu “5” và chữa PP cũng tương đối an toàn để chứa nước lạnh nhưng phải khử trùng trước khi sử dụng.
2. Cẩn trọng với vi khuẩn
Chai nhựa đã qua sử dụng có thể là ổ chứa nhiều vi khuẩn nguy hiểm và độc hại. Trên thực tế, mức độ vi sinh vật trong những chai này thường vượt quá giới hạn an toàn cho sức khỏe chúng ta. Tuy nhiên, việc rửa chai cũng không đảm bảo, chúng ta có thể uống phải các chất độc, thậm chí nhiễm virus gây viêm gan A và một số loại vi khuẩn, virus tiềm ẩn khác. Theo các số liệu điều tra, miệng chai là nơi chứa lượng lớn vi khuẩn nhất, tuy nhiên đây cũng là khu vực không được vệ sinh thường xuyên.
3. Bí ẩn về nguồn nước
Nhiều doanh nghiệp quảng cáo nguồn nước của họ có nguồn gốc từ suối khoáng. Tuy nhiên, sự thật là nước đóng chai chúng ta mua chẳng khác gì loại nước lọc chúng ta uống ở nhà.
4. Cẩn trọng với các loại nước đóng chai có hương vị
Các công ty nước đóng chai cũng quảng cáo bán các sản phẩm nước có thêm hương vị để thu hút người tiêu dùng. Họ cũng thường xuyên quảng cáo rằng loại nước uống hương vị này tốt cho sức khỏe hơn các loại đồ uống khác. Tuy nhiên, đôi khi các loại nước này có thể chứa nhiều đường như soda do các thành phần chứa đường núp bóng dưới nhiều cái tên khác nhau. *Theo Step to Health
Nguồn: cafef.vn

